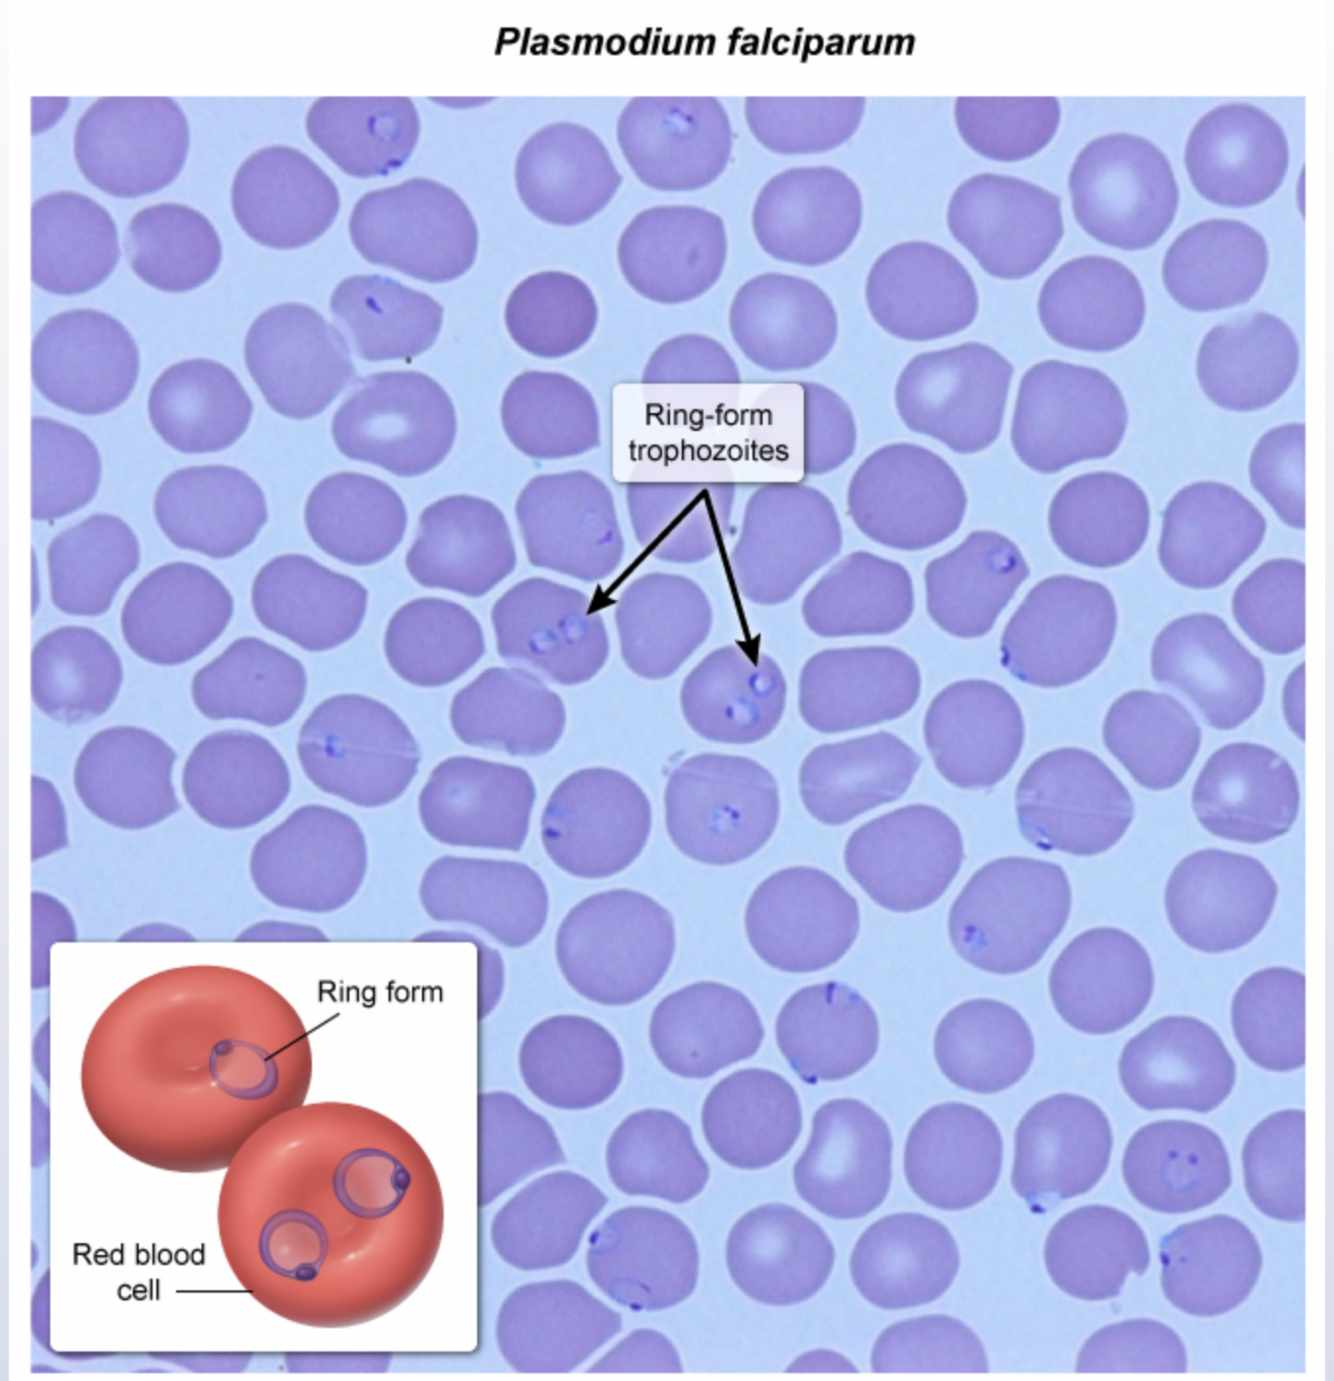
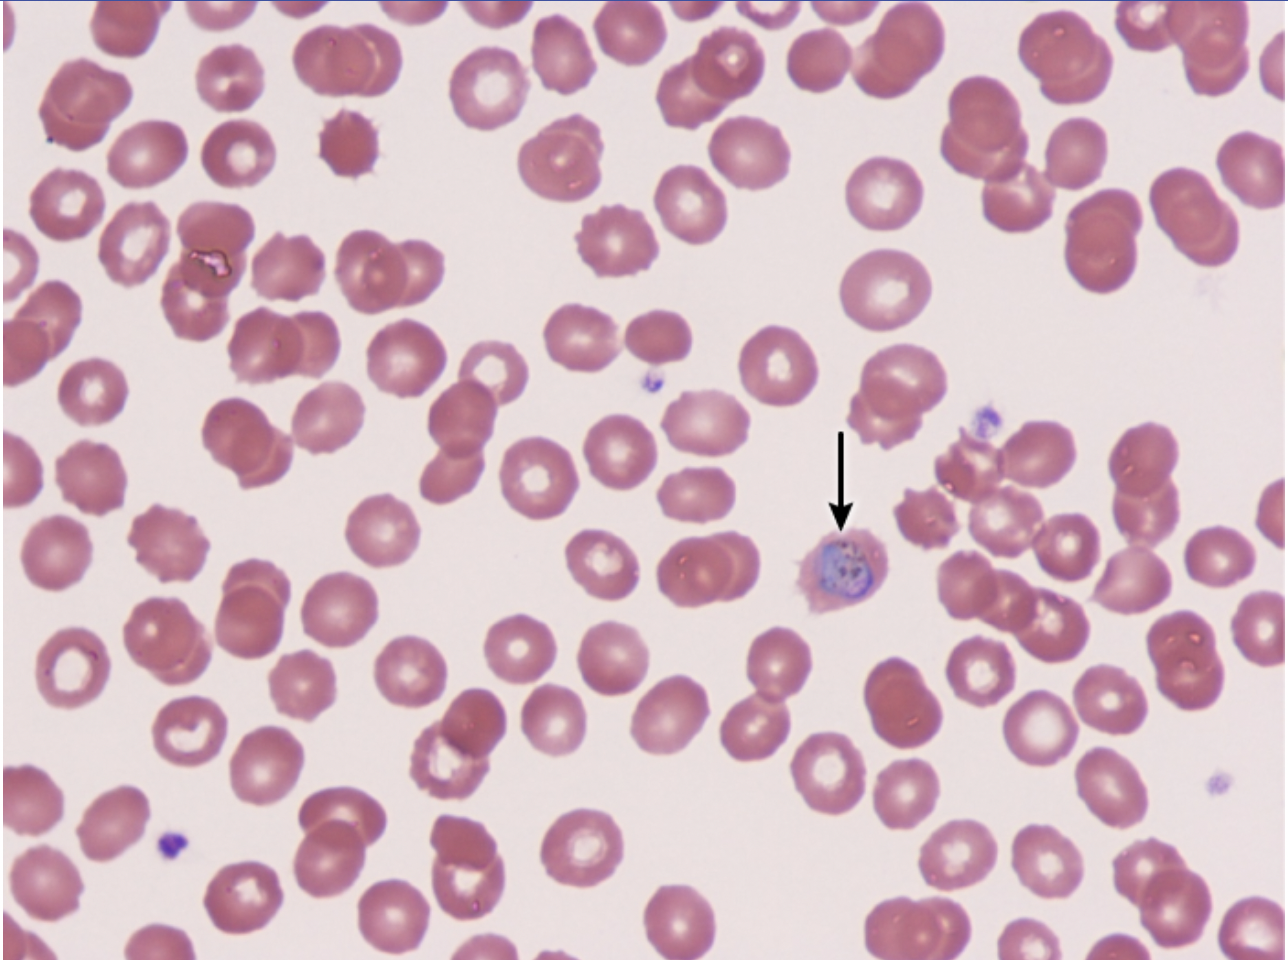

Aspergillus in relation to liver
fungus that produces **aflatoxin; contaminate in CORN; high dietary intake is associated with hepatocellular carcinoma (HCC); non-industrialized countries
Clonorchis sinensis in ascending cholangitis
Watch for Chinese liver fluke, may have just consumed sushi - helminth found in infected fish; you will see peripheral eosinophilia
Strep Bovis
normal colonic bacteria; gram + cocci and gamma hemolytic; Lancefield group D; cases bacteremia and **endocarditis; STRONGLY associated w/ colon cancer
pt w/ Step Bovis organism identified (endocarditis), what test should you do next?
Colonoscopy; STRONGLY associated w/ colon cancer
Malaria
caused by Plasmodium falciparum on blood smear RBCs will have multiple small rings representing developing trophozoites; antimalarials such as chloroquine, atovaquone-proguanil or artemisinins
Acute exacerbation of COPD due to viruses
the most common viral pathogens are rhinoviruses, influenza and respiratory syncytial virus
Treponema pallidum gold standard diagnosis
single, painless ulcer at inoculation site with heaped-up borders and clean base; pt w early syphilis often have false-negative initial serologic testing; direct visualization of the organism by dark-field microscopy or fluorescent antibody testing is gold standard
Haemophilus influenza
commonly causes epiglottis causing inspiratory stridor, dyspnea and severe agitation; major virulence factor is polysaccharide capsule which is composed of polyribosylribitol phosphate (PRP)
Disseminated gonococcal infection
when Neisseria gonorrhoeae spreads from the GU tract to the bloodstream; confined diagnosis w Thayer-martin media (chocolate agar); infection spread via sexual contact and prevented via consistent condom use

Phthirus pubis
pubic louse w crab-like claws that allow it to grab pubic hair; transmitted via skin to skin contact and causes intense pruritus; eggs can visualized on exam; tx is topical permethrin

Ebstein-Barr virus (EBV)
commonly infects B cells stimulating them to enter the cell cycle and proliferate continuously; oncogenic virus promotes heterophiles antibody production; heterophiles antibody test is sensitive and highly specific for EBV

CMV pneumonitis
in transplant pts, pneumonia w intranuclear and cytoplasmic inclusion bodies histologically points to opportunities infection w CMV; enveloped virus that contains dsDNA

Azoles
anti fungal med that inhibits the demethylation of lanosterol to ergosterol which is an important component of the cell membrane; they use the fungal P450 enzymes and also suppress the human P450 system resulting in many drug-drug interactions

Tertiary syphillis
can result in thoracic aortic aneurysm; if aneurysm compresses adjacent structures and dilates the aortic valve ring, a murmur and mediastinal widening can be present; pathogenesis begins w vasa vasorum endarteritis and obliteration

Acute exacerbation of COPD (bacterial cause)
3 most common bacteria during AECOPD are nontypeable Haemophilus, influenza, Moraxella
Acute exacerbation of COPD (viral cause)
3 most common bacteria during AECOPD are: rhinovirus, influenza, and RSV
Staph epidermidis
gram (+) coccus that grows in clusters (similar to staph aureus) but is coagulase-NEG; common cause of infection in pts with prosthetic devices (artificial joints/heart valves); susceptible to novobiocin (unlike Staph saprophyticus)

Novobiocin
antibiotic that is used to differentiate Staph saprophyticus (resistant) from Staph epidermidis (sensitive)
Replication of Hep B
occurs within newly synthesized capsid through the action of reverse transcriptase on an RNA template; the mature capsid contains partially ds circular DNA and reverse transcriptase
Coxsackie virus genome
with in the Picornaviridae family and composed of icosahedral nucleocapsid and a (+) ssRNA genome
Alcohol-based disinfectants kill which type of viruses
enveloped viruses (ex: influenza) by dissolving their outer lipid envelope
Influenza
enveloped orthomyxovirus w segmented, negative-sense, ssRNA genome; transmission is by contaminated, large particle droplets (droplet precautions)
Media for Neisseria
a selective media such as Thayer-Martin

malaria